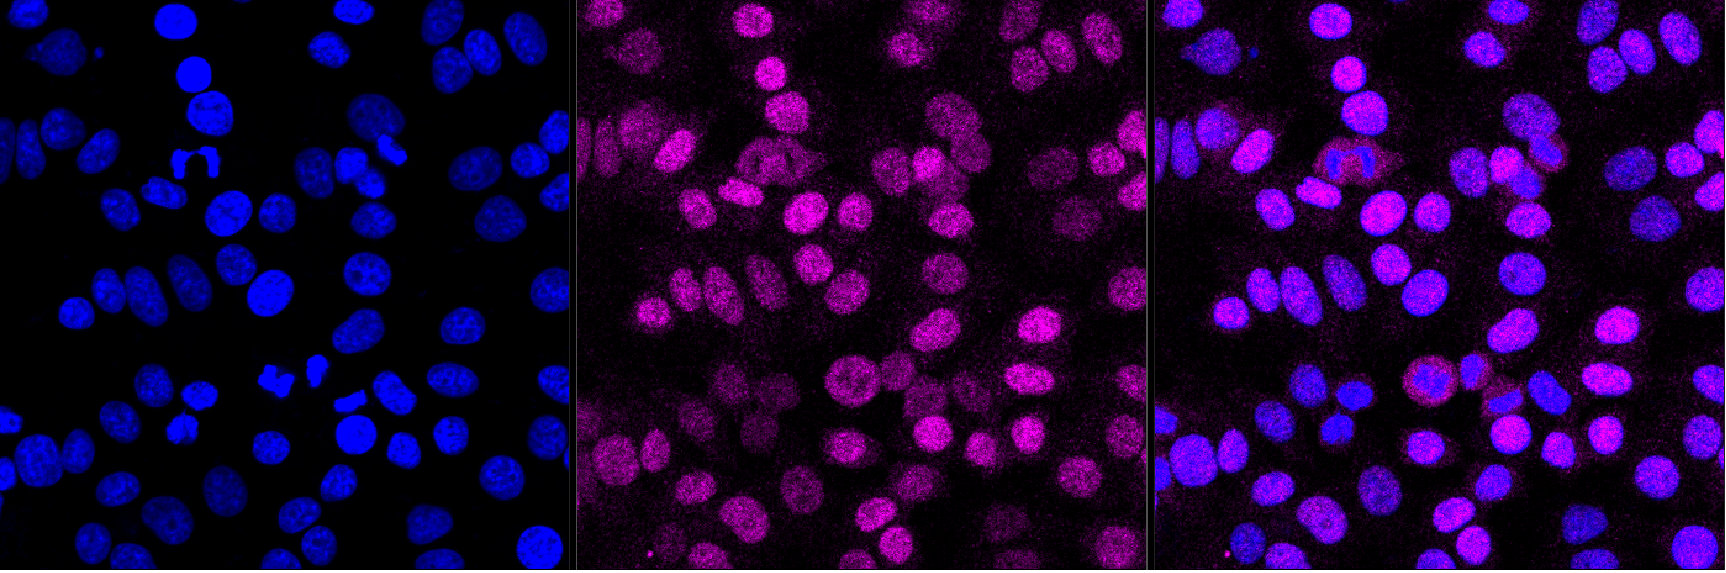

UBE2T Recombinant Monoclonal Antibody
-
中文名稱:UBE2T Recombinant Monoclonal Antibody
-
貨號(hào):CSB-RA211477A0HU
-
規(guī)格:¥1320
-
圖片:
-
Flow cytometric analysis of UBE2T expression in HepG2 cells using UBE2T antibody. Green, isotype control; red, UBE2T.
-
Immunocytochemical staining of HepG2 cells with UBE2T antibody. Nuclei were stained blue with DAPI; UBE2T was stained magenta with Alexa Fluor? 647. Images were taken using Leica stellaris 5. Protein abundance based on laser Intensity and smart gain: Medium. Scale bar, 20 μm.
-
Western blotting analysis using UBE2T antibody. Total cell lysates (30 μg) from various cell lines were loaded and separated by SDS-PAGE. The blot was incubated with UBE2T antibody and HRP-conjugated goat anti-rabbit secondary antibody respectively.
-
-
其他:
產(chǎn)品詳情
-
Uniprot No.:
-
基因名:UBE2T
-
別名:UBE2T; Ubiquitin Conjugating Enzyme E2 T; HSPC150; FANCT; Cell Proliferation-Inducing Gene 50 Protein; Ubiquitin-Conjugating Enzyme E2 T; E2 Ubiquitin-Conjugating Enzyme T; Ubiquitin Carrier Protein T; Ubiquitin-Protein Ligase T; HSPC150 Protein Similar To Ubiquitin-Conjugating Enzyme; Ubiquitin-Conjugating Enzyme E2T (Putative); Ubiquitin-Conjugating Enzyme E2T; Ubiquitin Conjugating Enzyme E2T; EC 2.3.2.23; PIG50
-
反應(yīng)種屬:Human
-
免疫原:Recombinant Human UBE2T protein
-
免疫原種屬:Homo sapiens (Human)
-
標(biāo)記方式:Non-conjugated
-
克隆類型:Monoclonal
-
抗體亞型:Rabbit IgG
-
純化方式:Affinity-chromatography
-
克隆號(hào):22G5
-
濃度:It differs from different batches. Please contact us to confirm it.
-
保存緩沖液:Rabbit IgG in PBS (pH 7.4) containing 50% glycerol, and 0.02% sodium azide.
-
產(chǎn)品提供形式:Liquid
-
應(yīng)用范圍:ELISA, WB, FC, ICC
-
推薦稀釋比:
Application Recommended Dilution WB 1:1000-1:5000 FC 1:200-1:2000 ICC 1:100-1:1000 -
Protocols:
-
儲(chǔ)存條件:Upon receipt, store at -20°C or -80°C. Avoid repeated freeze.
-
貨期:Basically, we can dispatch the products out in 1-3 working days after receiving your orders. Delivery time maybe differs from different purchasing way or location, please kindly consult your local distributors for specific delivery time.
-
用途:For Research Use Only. Not for use in diagnostic or therapeutic procedures.
相關(guān)產(chǎn)品
靶點(diǎn)詳情
-
功能:Accepts ubiquitin from the E1 complex and catalyzes its covalent attachment to other proteins. Catalyzes monoubiquitination. Involved in mitomycin-C (MMC)-induced DNA repair. Acts as a specific E2 ubiquitin-conjugating enzyme for the Fanconi anemia complex by associating with E3 ubiquitin-protein ligase FANCL and catalyzing monoubiquitination of FANCD2, a key step in the DNA damage pathway. Also mediates monoubiquitination of FANCL and FANCI. May contribute to ubiquitination and degradation of BRCA1. In vitro able to promote polyubiquitination using all 7 ubiquitin Lys residues, but may prefer 'Lys-11'-, 'Lys-27'-, 'Lys-48'- and 'Lys-63'-linked polyubiquitination.
-
基因功能參考文獻(xiàn):
- Results show that UBE2T expression was increased in gastric tumors. Its suppression altered the expression of epithelial-mesenchymal transition factors and inhibited growth and colony formation, increased G2/M phase cell cycle arrest, and promoted apoptosis in gastric cancer cells. These findings provide evidence that UBE2T plays a critical role in gastric cancer. PMID: 28427240
- High UBE2T expression is associated with nasopharyngeal carcinoma. PMID: 26943030
- Collectively, our findings suggest UBE2T serves as a promising prognostic factor for HCC and functions as an oncogene. The newly identified miR-543/UBE2T/p53 axis may represent a new potential therapeutic target for HCC intervention. PMID: 28935368
- report the identification of a new allosteric pocket on Ube2T through a fragment screening using biophysical methods. Several fragments binding to this site inhibit ubiquitin conjugation in vitro PMID: 28437106
- Results showed that UBE2T was overexpressed in osteosarcoma tissues and cell lines. Moreover, UBE2T knockdown inhibited osteosarcoma cell proliferation, migration, and invasion. PMID: 27712593
- UBE2T plays an important role in the tumorigenesis of gastric cancer and could act as a potential independent prognostic factor for cancer therapy. PMID: 27020591
- Identify critical roles of UBE2T in prostate cancer development and progression. PMID: 26308072
- we identified UBE2T as a bona fide FA gene (FANCT) that also may be a rare cancer susceptibility gene. PMID: 26085575
- UBE2T is the primary E2 of the FA pathway required for FANCD2 and FANCI activation. PMID: 26119737
- Mutations in the gene encoding the E2 conjugating enzyme UBE2T cause Fanconi anemia PMID: 26046368
- hypoxic conditions down-regulate UBE2T expression which correlates with an increased sensitivity to crosslinking agents consistent with a defective Fanconi anemia pathway PMID: 21722982
- UBE2T is the ubiquitin-conjugating enzyme (E2) in the Fanconi anemia pathway and has a self-inactivation mechanism that could be important for negative regulation of the Fanconi anemia pathway. PMID: 16916645
- UBE2T was significantly upregulated in lung cancer tissue and cell lines, suggesting involvement of UBE2T in the malignant cell phenotype. PMID: 18667844
- This work therefore establishes a system that provides mechanistic insight into the functions of FANCL and FANCI in the catalysis of FANCD2 monoubiquitination. PMID: 19111657
- Upon the occurrence of DNA damage, FANCI becomes monoubiquitinated on Lys-523 by the UBE2T-FANCL pair. PMID: 19589784
- Our data imply a critical role of UBE2T in development and/or progression of breast cancer through the interaction with and the regulation of the BRCA1/BARD1 complex. PMID: 19887602
顯示更多
收起更多
-
相關(guān)疾病:Fanconi anemia complementation group T (FANCT)
-
亞細(xì)胞定位:Nucleus. Note=Accumulates to chromatin.
-
蛋白家族:Ubiquitin-conjugating enzyme family
-
數(shù)據(jù)庫(kù)鏈接:
Most popular with customers
-
-
YWHAB Recombinant Monoclonal Antibody
Applications: ELISA, WB, IHC, IF, FC
Species Reactivity: Human, Mouse, Rat
-
Phospho-YAP1 (S127) Recombinant Monoclonal Antibody
Applications: ELISA, WB, IHC
Species Reactivity: Human
-
-
-
-
-